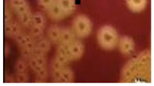
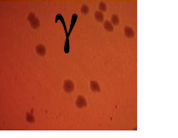
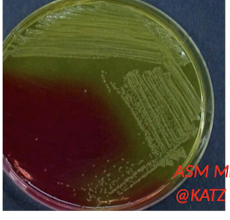
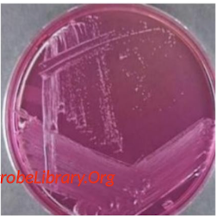
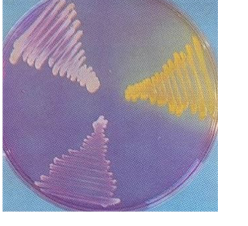
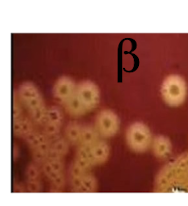

What kind of bacteria is seen in this image?

Staphylococcus
What are the 2 main culture media for growth of staphylococcus bacteria?
Mannitol salt agar containing high salt (NaCl) concentration (6.5–10%)
2. Blood agar β α γ
What kind of bacteria is staphylococcus? Is it catalase positive or negative? Is it motile? Does it form spores?
Gram positive cocci arranged in grape-like clusters • Facultative anaerobe • Non-motile (non-flagellated) • Non-spore forming • Catalase positive (detoxify H2O2) • Grow on media containing high salt (> 6.5-10%)
✓ E.g. Mannitol salt agar
What bacteria does manitol salt agar support the growth of? What bacteria does it inhibit growth of?
• It selectively supports growth of the following Gram-positive bacteria:
1. Staphylococcus
• However, it inhibits growth of most of:
In this image what kind of staphylococcus is seen?
A.) Alpha
B.) Beta
C.) Gamma
B.) Beta

In this image what kind of staphylococcus is seen?
A.) Alpha
B.) Beta
C.) Gamma

A.) Alpha

In this image what kind of staphylococcus is seen?
A.) Alpha
B.) Beta
C.) Gamma

c.) gamma
What staphylococcus bacteria causes this growth on a manitol salt agar plate? What cases the yellow coloring?
This is S aureus. It ferments manitol and changes the color of the agar from red to yellow.
What staphylococcus bacteria does not ferment manitol and uses this regular manitol salt agar media?
S. Epidermidis
S. epidermidis does not ferment manitol and no agar color change.
What Staphylococcus bacteria grows on this purple agar base which contains 1% maltose? What is causing the yellow colony? The white colony? The bottom colony?
Purple agar base containing 1% maltose:
✓ S. intermedius (left)
✓ S. aureus (right; yellow)
✓ S. hyicus (bottom)
What is the purpose of blood agar?
t allows determination of the type of hemolysin toxin produced by the isolates
What does an alpha staphylococcus look like on an blood agar? What does it mean?
Alpha is an incomplete hemolysis. The color of these colonies are usually green.

What does an Beta staphylococcus look like on an blood agar? What does it mean?
The colonies would be clear and produce yellow haze around it. This is from complete hemolysis.
What does an Gamma staphylococcus look like on an blood agar? What does it mean?
Gamma - has no change in media, it shows no hemolyis
What color is S. Aureus on blood agar? What does it mean when they are yellow in color? Where does the yellow pigment come from?
What methods are available to diagnose staphylococcus isolates from suspected cases?
What happens to a catalase positive bacteria if it is placed on a slide with H2O2?
It will bubble within 1-3 seconds

What are the indicators of highly pathogenic species?
What will you see in a sample that is coagulase +?
The fluid will be cloudy
What does a VP test, test for?
Acetonin production
+ will be red
What does a beta- galactosidase test, test for?
Called lactase test/ Looks to see if the bacteria ferments lactose.
What strains of staphylococcus is typically in pets?
S. scleiferi (beta hemolysis +, VP positive, trehalose negative)
S. Pseudointermedius ( trehalose positive , VP negative, Beta hemolysis +)
What strains of staphylococcus are emerging?
S. felis ( Coagulase negative, VP negative, Lactase positive)
S. Chromogenes (Coagulase negative, VP negative, Lactase negative)
Which staphylococcis strains are more pathogenic?
Coagulase positive strains are more pathogenic particularly strains with beta-hemolysis
ie. s aureus, s. schleiferi, s. pseudointermedius, s. delphini